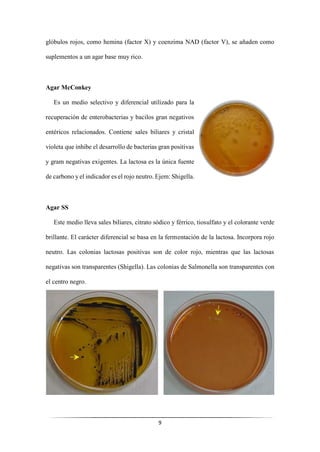
9
glóbulos rojos, como hemina (factor X) y coenzima NAD (factor V), se añaden como
suplementos a un agar base muy rico.
Agar McConkey
Es un medio selectivo y diferencial utilizado para la
recuperación de enterobacterias y bacilos gran negativos
entéricos relacionados. Contiene sales biliares y cristal
violeta que inhibe el desarrollo de bacterias gran positivas
y gram negativas exigentes. La lactosa es la única fuente
de carbono y el indicador es el rojo neutro. Ejem: Shigella.
Agar SS
Este medio lleva sales biliares, citrato sódico y férrico, tiosulfato y el colorante verde
brillante. El carácter diferencial se basa en la fermentación de la lactosa. Incorpora rojo
neutro. Las colonias lactosas positivas son de color rojo, mientras que las lactosas
negativas son transparentes (Shigella). Las colonias de Salmonella son transparentes con
el centro negro.

Este documento presenta información sobre medios de cultivo y técnicas de tinción utilizadas en el diagnóstico de enfermedades infecciosas. Explica los diferentes tipos de medios de cultivo, incluyendo sus características, composición y usos. También describe métodos de tinción como la tinción de Gram, tinción para bacterias ácido-alcohol resistentes y tinción para esporas. Finalmente, introduce conceptos sobre serología, diagnóstico molecular y pruebas como PCR. El documento provee información fundamental sobre herramientas de